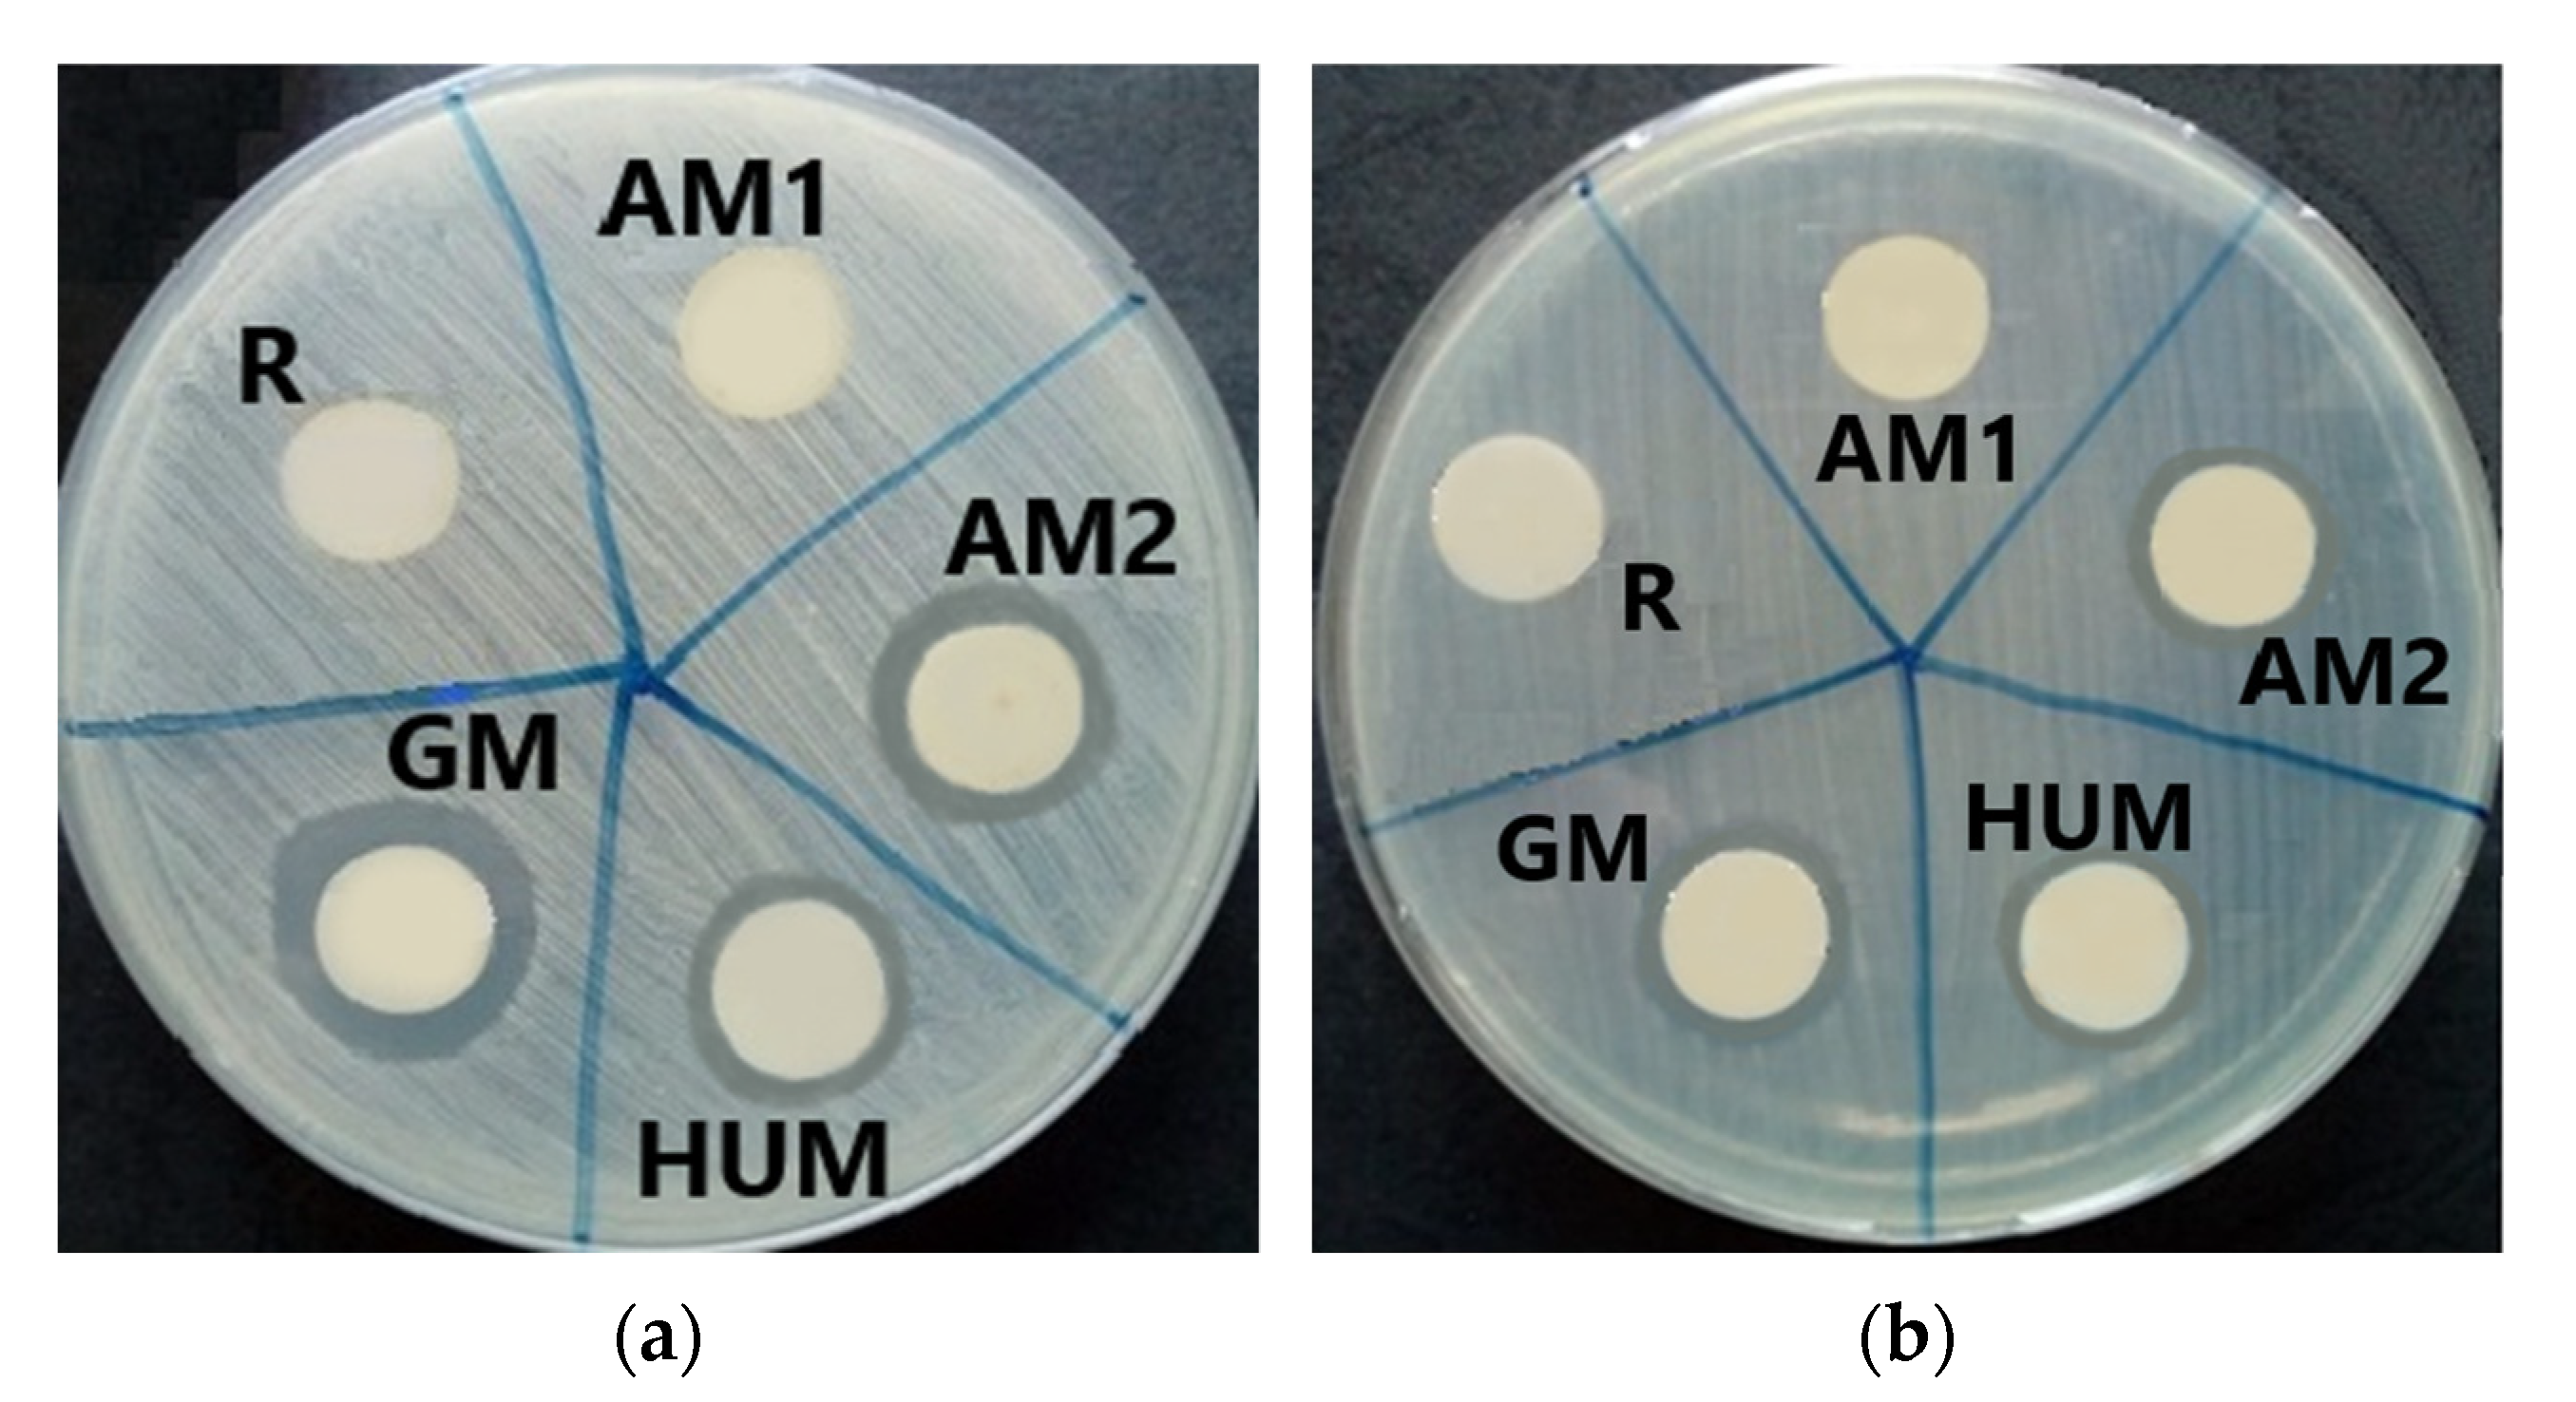
Materials 14 07031 g008

Additives Imparting Antimicrobial Properties to Acrylic Bone Cements
Abstract
:1. Introduction
2. Materials and Methods
- mw—mass of the wet bone cement samples,
- mf—mass of the bone cement samples after drying, and
- m0—initial mass of the bone cement samples.
- mf—mass of the bone cement samples after drying; and
- m0—initial mass of the bone cement samples.
3. Results and Discussion
3.1. SEM Analysis
3.2. Contact Angle
3.3. Hydration Degree
3.4. Degradation Degree
3.5. Antimicrobial Tests Results
3.6. MTT Assay Results
4. Conclusions
Author Contributions
Funding
Institutional Review Board Statement
Informed Consent Statement
Data Availability Statement
Conflicts of Interest
References
- Deb, S. Orthopedic Bone Cement. In Wiley Encyclopedia of Biomedical Engineering; Metin, A., Ed.; John Wiley & Sons: Hoboken, NJ, USA, 2006; ISBN 9780471249672. [Google Scholar]
- De Santis, R.; Russo, T.; Rau, J.V.; Papallo, I.; Martorelli, M.; Gloria, A. Design of 3D Additively Manufactured Hybrid Structures for Cranioplasty. Materials 2021, 14, 181. [Google Scholar] [CrossRef]
- Botez, P.; Sirbu, P.; Simion, L.; Munteanu, F.; Antoniac, I. Application of a biphasic macroporous synthetic bone substitutes CERAFORM(A (R)): Clinical and histological results. Eur. J. Orthop. Surg. Traumatol. 2009, 19, 387–395. [Google Scholar] [CrossRef]
- Rivis, M.; Pricop, M.; Talpos, S.; Ciocoiu, R.; Antoniac, I.; Gheorghita, D.; Trante, O.; Moldovan, H.; Grigorescu, G.; Seceleanu, V.; et al. Influence of the bone cements processing on the mechanical properties in cranioplasty. Rev. Chim. 2018, 69, 990–993. [Google Scholar] [CrossRef]
- Ginebra, M.P.; Montufar, E.B. Cements as bone repair materials. In Bone Repair Biomaterials, 2nd ed.; Pawelec, K., Planell, J.A., Eds.; Woodhead Publishing: Sawston, UK, 2019; pp. 233–271. ISBN 9780081024515. [Google Scholar]
- Dunne, J.N.; Wang, C.S. Acrylic cements for bone fixation in joint replacement. In Joint Replacement Technology; Revel, P.A., Ed.; Woodhead Publishing: Sawston, UK, 2014; pp. 212–256. ISBN 978-1-84569-245-2. [Google Scholar]
- Zhu, W.; Liu, F.; Yu, B.; He, J. Preparation of antibacterial acrylic bone cement with methacrylate derived from benzothiazole. J. Mech. Behav. Biomed. Mater. 2021, 117, 1–7. [Google Scholar] [CrossRef]
- Alonso, L.M.; Torres, I.F.; Zayas Tamayo, Á.M.; Ledea Lozano, O.E.; Ramos, I.D.; García-Menocal, J.D.; Rios-Donato, N.; Mendizábal, E. Antibacterial effect of acrylic bone cements loaded with drugs of different action’s mechanism. J. Infect. Dev. Ctries. 2019, 13, 487–495. [Google Scholar] [CrossRef] [PubMed]
- Bozic, K.J.; Kurtz, S.M.; Lau, E.; Ong, K.; Chiu, V.; Vail, T.P.; Rubash, H.E.; Berry, D.J. The epidemiology of revision total knee arthroplasty in the United States. Clin. Orthop. Relat. Res. 2010, 468, 45–51. [Google Scholar] [CrossRef] [PubMed] [Green Version]
- Moriarty, T.F.; Kuehl, R.; Coenye, T.; Metsemakers, W.J.; Morgenstern, M.; Schwarz, E.M.; Riool, M.; Zaat, S.A.J.; Khana, N.; Kates, S.L.; et al. Orthopaedic device-related infection: Current and future interventions for improved prevention and treatment. EFORT Open Rev. 2016, 1, 89–99. [Google Scholar] [CrossRef]
- Chen, L.; Tang, Y.; Zhao, K.; Zha, X.; Liu, J.; Bai, H.; Wu, Z. Fabrication Of The Antibiotic-Releasing Gelatin/PMMA Bone Cement. Colloids Surf. B Biointerfaces 2019, 183, 1–11. [Google Scholar] [CrossRef]
- Lacy, M.K.; Nicolau, D.P.; Nightingale, C.H.; Quintiliani, R. The pharmacodynamics of aminoglycosides. Clin. Infect. Dis. 2007, 27, 23–27. [Google Scholar] [CrossRef] [Green Version]
- Slane, J.; Gietman, B.; Squire, M. Antibiotic elution from acrylic bone cement loaded with high doses of tobramycin and vancomycin. J. Orthop. Res. 2018, 36, 1078–1085. [Google Scholar] [CrossRef] [Green Version]
- Neut, D.; De Groot, E.P.; Kowalski, R.S.Z.; Van Horn, J.R.; Van Der Mei, H.C.; Busscher, H.J. Gentamicin-loaded bone cement with clindamycin or fusidic acid added: Biofilm formation and antibiotic release. J. Biomed. Mater. Res. A 2005, 73, 165–170. [Google Scholar] [CrossRef]
- Snir, N.; Meron-Sudai, S.; Deshmukh, A.J.; Dekel, S.; Ofek, I. Antimicrobial Properties and Elution Kinetics of Linezolid from Polymethylmethacrylate. Orthopedics 2013, 36, 1412–1417. [Google Scholar] [CrossRef] [PubMed] [Green Version]
- Anagnostakos, K.; Kelm, J.; Regitz, T.; Schmitt, E.; Jung, W. In vitro evaluation of antibiotic release from and bacteria growth inhibition by antibiotic-loaded acrylic bone cement spacers. J. Biomed. Mater. Res. B Appl. Biomater. 2005, 72, 373–378. [Google Scholar] [CrossRef] [PubMed]
- Parra-Ruíz, F.J.; González-Gómez, A.; Fernández-Gutiérrez, M.; Parra, J.; García-García, J.; Azuara, G.; De la Torre, B.; Buján, J.; Ibarra, B.; Duocastella-Codina, L.; et al. Development of advanced antibiotic loaded bone cement spacers for arthroplasty associated infections. Int. J. Pharm. 2017, 522, 11–20. [Google Scholar] [CrossRef]
- Paz, E.; Sanz-Ruiz, P.; Abenojar, J.; Vaquero-Martín, J.; Forriol, F.; Del Real, J.C. Evaluation of elution and mechanical properties of high-dose antibiotic-loaded bone cement: Comparative “in vitro” study of the influence of vancomycin and cephazolin. J. Arthroplast. 2015, 30, 1423–1429. [Google Scholar] [CrossRef]
- Hellmark, B.; Unemo, M.; Nilsdotter-Augustinsson, A.; Soderquist, B. Antibiotic susceptibility among Staphylococcus epidermidis isolated from prosthetic joint infections with special focus on rifampicin and variability of the rpoB gene. Clin. Microbiol. Infect. 2009, 15, 238–244. [Google Scholar] [CrossRef] [PubMed] [Green Version]
- Thornes, B.; Murray, P.; Bouchier-Hayes, D. Development of resistant strains of Staphylococcus epidermidis on gentamicin-loaded bone cement in vivo. J. Bone Jt. Surg. 2002, 84, 758–760. [Google Scholar] [CrossRef]
- Cavalu, S.; Banica, F.; Gruian, C.; Vanea, E.; Goller, G.; Simon, V. Microscopic and spectroscopic investigation of bioactive glasses for antibiotic controlled release. J. Mol. Struct. 2013, 1040, 47–52. [Google Scholar] [CrossRef]
- Khaled, S.M.; Charpentier, P.A.; Rizkalla, A.S. Physical and mechanical properties of PMMA bone cement reinforced with nano-sized titania fibers. J. Biomater. Appl. 2011, 25, 515–537. [Google Scholar] [CrossRef]
- Slane, J.; Vivanco, J.; Rose, W.; Ploeg, H.L.; Squire, M. Mechanical, material, and antimicrobial properties of acrylic bone cement impregnated with silver nanoparticles. Mater. Sci. Eng. C 2015, 48, 188–196. [Google Scholar] [CrossRef]
- Oei, J.D.; Zhao, W.W.; Chu, L.; Desilva, M.N.; Ghimire, A.; Rawls, H.R.; Whang, K. Antimicrobial acrylic materials with in situ generated silver nanoparticles. J. Biomed. Mater. Res. B Appl. Biomater. 2012, 100, 409–415. [Google Scholar] [CrossRef] [PubMed]
- Wekwejt, M.; Michalska-Sionkowska, M.; Bartmański, M.; Nadolska, M.; Łukowicz, K.; Pałubicka, A.; Osyczka, A.M.; Zieliński, A. Influence of several biodegradable components added to pure and nanosilver-doped PMMA bone cements on its biological and mechanical properties. Mater. Sci. Eng. C 2020, 117, 111286. [Google Scholar] [CrossRef] [PubMed]
- Russo, T.; Gloria, A.; De Santis, R.; D’Amora, U.; Balato, G.; Vollaro, A.; Oliviero, O.; Improta, G.; Triassi, M.; Ambrosio, L. Preliminary focus on the mechanical and antibacterial activity of a PMMA-based bone cement loaded with gold nanoparticles. Bioact. Mater. 2017, 2, 156–161. [Google Scholar] [CrossRef]
- Phakatkar, A.H.; Shirdar, M.R.; Qi, M.; Taheri, M.M.; Narayanan, S.; Foroozan, T.; Sharifi-Asl, S.; Huang, Z.; Agrawal, M.; Lu, Y.; et al. Novel PMMA bone cement nanocomposites containing magnesium phosphate nanosheets and hydroxyapatite nanofibers. Mater. Sci. Eng. C 2020, 109, 110497. [Google Scholar] [CrossRef]
- Russo, T.; De Santis, R.; Gloria, A.; Barbaro, K.; Altigeri, A.; Fadeeva, I.V.; Rau, J. Modification of PMMA Cements for Cranioplasty with Bioactive Glass and Copper Doped Tricalcium Phosphate Particles. Polymers 2020, 12, 37. [Google Scholar] [CrossRef] [Green Version]
- Cojocaru, F.D.; Balan, V.; Popa, M.I.; Lobiuc, A.; Antoniac, A.; Antoniac, I.V.; Verestiuc, L. Biopolymers—Calcium phosphates composites with inclusions of magnetic nanoparticles for bone tissue engineering. Int. J. Biol. Macromol. 2019, 125, 612–620. [Google Scholar] [CrossRef]
- Dascalu, C.A.; Maidaniuc, A.; Pandele, A.M.; Voicu, S.I.; Machedon-Pisu, T.; Stan, G.E.; Cimpean, A.; Mitran, V.; Antoniac, I.V.; Miculescu, F. Synthesis and characterization of biocompatible polymer-ceramic film structures as favorable interface in guided bone regeneration. Appl. Surf. Sci. 2019, 494, 335–352. [Google Scholar] [CrossRef]
- Kumar, A.; Kargozar, S.; Baino, F.; Han, S.S. Additive manufacturing methods for producing hydroxyapatite and hydroxyapatite-based composite scaffolds: A review. Front. Mater. 2019, 6, 313. [Google Scholar] [CrossRef]
- Radhi, A.; Mohamad, D.; Rahman, F.S.; Abdullah, A.M.; Hasan, H. Mechanism and factors influence of graphene based nanomaterials antimicrobial activities and application in dentistry. J. Mater. Res. Technol. 2021, 11, 1290–1307. [Google Scholar] [CrossRef]
- Sarosi, C.; Biris, A.R.; Antoniac, A.; Boboia, S.; Alb, C.; Antoniac, I.; Moldovan, M. The nanofiller effect on properties of experimental graphene dental nanocomposites. J. Adhes. Sci. Technol. 2016, 30, 1779–1794. [Google Scholar] [CrossRef]
- Sartoratto, A.; Machado, A.L.M.; Delarmelina, C.; Figueira, G.M.; Duarte, M.C.T.; Rehder, V.L.G. Composition and antimicrobial activity of essential oils from aromatic plants used in Brazil. Braz. J. Microbiol. 2004, 34, 1517–1520. [Google Scholar] [CrossRef] [Green Version]
- Saeed, S.; Naim, A.; Tariq, P. In vitro antibacterial activity of peppermint. Pak. J. Bot. 2006, 38, 869–872. [Google Scholar]
- Gordon, M.C.; David, J.N. Natural product drug discovery in the next millennium. Pharm. Biol. 2001, 139, 8–17. [Google Scholar]
- Bakkali, F.; Averbeck, S.; Averbeck, D.; Idaomar, M. Biological effects of essential oils—A review. Food Chem. Toxicol. 2008, 46, 446–475. [Google Scholar] [CrossRef] [PubMed]
- El Asbahani, A.; Miladi, K.; Badri, W.; Sala, M.; Addi, E.A.; Casabianca, H.; El Mousadik, A.; Hartmann, D.; Jilale, A.; Renaud, F.N.R.; et al. Essential oils: From extraction to encapsulation. Int. J. Pharm. 2015, 483, 220–243. [Google Scholar] [CrossRef]
- Kligler, B.; Chaudhary, S. Peppermint Oil. Am. Fam. Physician 2007, 75, 1027–1030. [Google Scholar] [PubMed]
- Briggs, C. Peppermint: Medicinal herb and flavoring agent. Can. Pharm. J. 1993, 126, 89–92. [Google Scholar]
- Anghel, I.; Holban, A.M.; Grumezescu, A.M.; Andronescu, E.; Ficai, A.; Anghel, A.G.; Maganu, M.; Lazar, V.; Chifiriuc, M.C. Modified wound dressing with phyto-nanostructured coating to prevent Staphylococcal and Pseudomonal biofilm development. Nanoscale Res. Lett. 2012, 7, 1–8. [Google Scholar] [CrossRef] [Green Version]
- Singh, R.; Shushni Muftah, A.M.; Belkheir, A. Antibacterial and antioxidant activities of Mentha piperita L. Arab. J. Chem. 2015, 8, 322–328. [Google Scholar] [CrossRef] [Green Version]
- Sokovic, M.D.; Vukojevic, J.; Marin, P.D.; Brkic, D.D.; Vajs, V.; Van Griensvenu, L.J.L.D. Chemical composition of essential oils of Thymus and Mentha species and their antifungal activities. Molecules 2009, 14, 238–249. [Google Scholar] [CrossRef]
- Almasian, A.; Najafi, F.; Eftekhari, M.; Shams Ardekani, M.R.; Sharifzadeh, M.; Khanavi, M. Preparation of Polyurethane/Pluronic F127 Nanofibers Containing Peppermint Extract Loaded Gelatin Nanoparticles for Diabetic Wounds Healing: Characterization, In Vitro, and In Vivo Studies. Evid. Based Complement. Altern. Med. 2021, 2021, 6646702. [Google Scholar] [CrossRef] [PubMed]
- Kasiri, N.; Fathi, M. Entrapment of peppermint oil using cellulose nanocrystals. Cellulose 2018, 25, 319–329. [Google Scholar] [CrossRef]
- Carbonell-Blasco, P.; Martín-Martínez, J.M.; Antoniac, I.V. Synthesis and characterization of polyurethane sealants containing rosin intended for sealing defect in annulus for disc regeneration. Int. J. Adhes. Adhes. 2013, 42, 11–20. [Google Scholar] [CrossRef]
- Attik, G.N.; Villat, C.; Hallay, F.; Pradelle-Plasse, N.; Bonnet, H.; Moreau, K.; Colon, P.; Grosgogeat, B. In vitro biocompatibility of a dentine substitute cement on human MG63 osteoblasts cells: Biodentine™ versus MTA®. Int. Endod. J. 2014, 47, 1133–1141. [Google Scholar] [CrossRef]
- Cavalu, S.; Antoniac, I.V.; Fritea, L.; Mates, I.M.; Milea, C.; Laslo, V.; Vicas, S.; Mohan, A. Surface modifications of the titanium mesh for cranioplasty using selenium nanoparticles coating. J. Adhes. Sci. Technol. 2018, 32, 2509–2522. [Google Scholar] [CrossRef]
- Cavalu, S.; Ratiu, C.; Ponta, O.; Simon, V.; Rugina, D.; Miclaus, V.; Akin, I.; Goller, G. Improving Osseointegration of Alumina/Zirconia Ceramic Implants by Fluoride Surface Treatment. Dig. J. Nanomater. Biostruct. 2014, 9, 797–808. [Google Scholar]
- Rajamony, L.L.; Gurupatham, B.G.A.; Roy, K.; Lim, J.B.P. Effect of super absorbent polymer on microstructural and mechanical properties of concrete blends using granite pulver. Struct. Concr. 2020, 22, E898–E915. [Google Scholar] [CrossRef]
- Rajamony, L.L.; Gurupatham, B.G.A.; Roy, K.; Lim, J.B.P. Influence of super absorbent polymer on mechanical, rheological, durability, and microstructural properties of self-compacting concrete using non-biodegradable granite pulver. Struct. Concr. 2020, 22, E1093–E1116. [Google Scholar] [CrossRef]
- Heise, S.; Forster, C.; Heer, S.; Qi, H.; Zhou, J.; Virtanen, S.; Lu, T.; Boccaccini, A.R. Electrophoretic deposition of gelatine nanoparticle/chitosan coatings. Electrochim. Acta 2019, 307, 318–325. [Google Scholar] [CrossRef]
- Chen, S.; Guo, Y.; Liu, R.; Wu, S.; Fang, J.; Huang, B.; Li, Z.; Chen, Z.; Chen, Z. Tuning surface properties of bone biomaterials to manipulate osteoblastic cell adhesion and the signaling pathways for the enhancement of early osseointegration. Colloids Surf. B 2018, 164, 58–69. [Google Scholar] [CrossRef] [PubMed]

| Samples | Composition | Antimicrobial Additive | |
|---|---|---|---|
| Powder | Liquid | ||
| R | PMMA, BPO, BaSO4 | MMA, BMA, DmpT, HQ | None |
| GM | PMMA, BPO, BaSO4 | MMA, BMA, DmpT, HQ | 5% gentamicin |
| HUM | PMMA, BPO, BaSO4, HAp | MMA, BMA, DmpT, HQ | 5% peppermint essential oil incorporated in hydroxyapatite |
| AM1 | PMMA, BPO, BaSO4 | MMA, BMA, DmpT, HQ | 2% silver nanoparticles incorporated in a ceramic glass |
| AM2 | PMMA, BPO, BaSO4 | MMA, BMA, DmpT, HQ | 4% silver nanoparticles incorporated in a ceramic glass |
| R | GM | HUM | AM1 | AM2 | |
|---|---|---|---|---|---|
| Contact angle, Ɵ [°], water | 71 | 85 | 58 | 55 | 67 |
| Contact angle, Ɵ [°], DIM | 27 | 40 | 31 | 51 | 41 |
| Contact angle, Ɵ [°], EG | 57 | 50 | 50 | 53 | 46 |
Publisher’s Note: MDPI stays neutral with regard to jurisdictional claims in published maps and institutional affiliations. |
© 2021 by the authors. Licensee MDPI, Basel, Switzerland. This article is an open access article distributed under the terms and conditions of the Creative Commons Attribution (CC BY) license (https://creativecommons.org/licenses/by/4.0/).
Share and Cite
Robu, A.; Antoniac, A.; Grosu, E.; Vasile, E.; Raiciu, A.D.; Iordache, F.; Antoniac, V.I.; Rau, J.V.; Yankova, V.G.; Ditu, L.M.; et al. Additives Imparting Antimicrobial Properties to Acrylic Bone Cements. Materials 2021, 14, 7031. https://doi.org/10.3390/ma14227031
Robu A, Antoniac A, Grosu E, Vasile E, Raiciu AD, Iordache F, Antoniac VI, Rau JV, Yankova VG, Ditu LM, et al. Additives Imparting Antimicrobial Properties to Acrylic Bone Cements. Materials. 2021; 14(22):7031. https://doi.org/10.3390/ma14227031
Chicago/Turabian StyleRobu, Alina, Aurora Antoniac, Elena Grosu, Eugeniu Vasile, Anca Daniela Raiciu, Florin Iordache, Vasile Iulian Antoniac, Julietta V. Rau, Viktoriya G. Yankova, Lia Mara Ditu, and et al. 2021. "Additives Imparting Antimicrobial Properties to Acrylic Bone Cements" Materials 14, no. 22: 7031. https://doi.org/10.3390/ma14227031
APA StyleRobu, A., Antoniac, A., Grosu, E., Vasile, E., Raiciu, A. D., Iordache, F., Antoniac, V. I., Rau, J. V., Yankova, V. G., Ditu, L. M., & Saceleanu, V. (2021). Additives Imparting Antimicrobial Properties to Acrylic Bone Cements. Materials, 14(22), 7031. https://doi.org/10.3390/ma14227031











